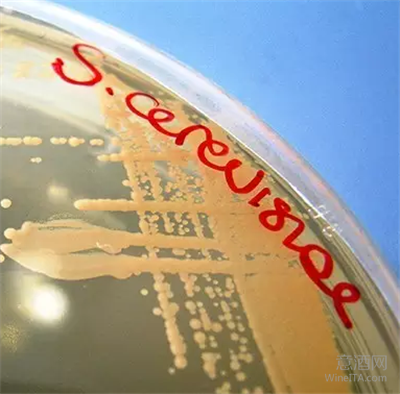

在葡萄酒的酿造过程中,从一串葡萄变成一瓶酒,期间经历了许多化学变化,而在这个过程中,有一种物质起着至关重要的左右,它就像是一个魔术师,将葡萄汁转化成了葡萄酒,它就是酵母菌。

生理特性
酵母菌(Yeast)是一种单细胞真菌,广泛存在于自然界。我们生活中食用的面包、馒头,饮用的啤酒、葡萄酒、酸奶、茶等食品饮料的制作都离不开这些酵母菌。作为一种单细胞生物,酵母菌早已存在于自然界。在距今3000多年前,人们就开始利用野生酵母菌制作发酵产品。直到1680年,显微镜的发明人,荷兰营养学家 Anton van leeuwenhoek 在他自己制作的显微镜下发现了酵母菌的存在。
酵母菌在低水含量的环境下就可以生存,能耐受的 pH 值为3.0~7.5(生长最适的 pH 值在4.5~5.0),能耐受冰点到47℃的温度,生长最适温度是20~30℃。酵母菌最适合生长环境的含糖量在15~20Brix。
另外,酵母菌可利用单糖中的果糖、葡萄糖、甘露糖和半乳糖和双糖中的麦芽糖和蜜二糖,三糖中的鼠李糖等碳源,可利用铵离子和多种氨基酸作为其生长的氮源,利用磷酸盐和磷酸酯类作为磷源,还有维生素作为其生长的生物素。
野生酵母
酵母菌属于酿酒酵母属(Saccharomyces),将葡萄汁(葡萄糖和果糖)变成葡萄酒的是其中的酿酒酵母(Saccharomyces Cervisiae)。
葡萄园的土壤、空气、葡萄藤、叶片和葡萄果梗和果皮上都存在着野生酵母,特别是在葡萄成熟的季节,我们经常可以看到葡萄果粒表面有一层白霜,里面就含有野生酵母菌群(个别葡萄种植者在葡萄上喷洒农药形成的白色斑状情况除外)。
野生酵母包括克勒克酵母(Kloechera)、梅氏酵母(Metschnikowia)、汉生酵母(Hansenula)、假丝酵母(Candida)和有孢汉生酵母(Hanseniaspora)。

在葡萄园里,这些野生酵母赖以生存的营养物质是葡萄的分泌物。由于酵母菌生长需要各种营养物质,在酿制贵腐酒时,葡萄皮已经严重被贵腐霉菌感染。这些霉菌可以带给葡萄酒特殊的风味,但也极大地消耗了葡萄中的维生素和矿物质。榨出的葡萄汁中含有的营养成分非常少。在酿酒过程添加酵母时,也需要同时添加酵母营养剂,以保证发酵过程顺利进行。

人们最初利用葡萄表皮和葡萄酒厂环境中的酵母酿制葡萄酒。这些酵母菌随着葡萄果皮的破碎进入到葡萄醪中,进行繁殖、发酵。
现在欧洲传统葡萄酒产区仍有少数的酒厂采用自然发酵的方式酿制葡萄酒。采用这种方式酿制出的葡萄酒,更多地反映了葡萄种植工艺和气候条件。